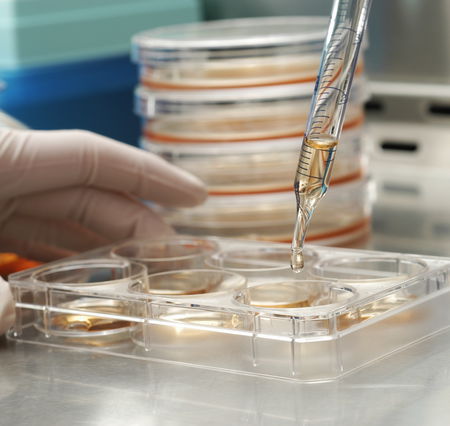
article-post

Agitalia e gli embrioni al Pertini!

Agitalia:Io è da tempo che cerco di segnalare questa fantomatica Agitalia, Agenzia per la Giustizia in Italia.
Da Dicembre ho scritto più volte ai giornali che pubblicavano i “comunicati stampa” di questa fantomatica Agenzia…comunicati che si sono quasi sempre rivelati BUFALE senza alcuna fonte reale!
Alcuni di voi mi avevano anche provato a spiegare che magari questa gente raccoglie lire italiane per rivenderle sul mercato della numismatica (cosa possibile, ma MAI SPIEGATA nei loro pezzi). Insomma a me quest’agenzia puzzava moltissimo.

E ora la cosa non puzza più solo a me, perché nel caso non ve ne siate accorti questa Agitalia è dietro agli svariati articoli sul nuovo scambio di embrioni all’Ospedale Pertini, scambio che sembra non ci sia mai stato, scambio che secondo chi ha studiato le carte sia stato costruito ad hoc falsificando documenti di vario tipo!

Chissà se finalmente i tanti GIORNALARI che mi avevano preso per il sedere quando spiegavo loro che Agitalia è FUFFA si stanno ricredendo, chissà se quel caporedattore del Messaggero a cui feci presente la cosa in Gennaio e che mi rispose in pessimo modo si sta mangiando le mani per non avermi dato retta. Son sicuro che non è così, son sicuro che visto quanto sono incapaci come giornalisti lo siano anche come esseri umani! L’unica persona che mi aveva dato retta sulla cosa è la brava Maddalena Balacco di Giornalettismo, che oggi mi ha segnalato la cosa ponendo l’accento sui due articoli che hanno pubblicato loro (peccato non ci abbiano citati come primi ad aver nasato che quell’Agenzia aveva qualcosa di marcio…peccato), due articoli che dimostrano come questa gente oggi che dovrebbe rispondere delle proprie azione sia sparita, non risponda al telefono e neppure alla mail.
Lo so, io non sono giornalista, non è un vero scoop quello che avevo fatto a Dicembre, ma ho goduto davvero tanto per questa storiella e ci tenevo che ne veniste messi al corrente anche voi!





